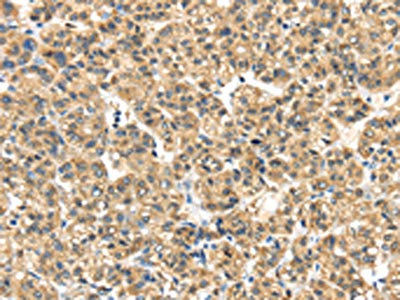

ME1 Antibody
-
中文名稱:ME1兔多克隆抗體
-
貨號:CSB-PA269233
-
規格:¥1100
-
圖片:
-
The image on the left is immunohistochemistry of paraffin-embedded Human thyroid cancer tissue using CSB-PA269233(ME1 Antibody) at dilution 1/35, on the right is treated with synthetic peptide. (Original magnification: ×200)
-
The image on the left is immunohistochemistry of paraffin-embedded Human liver cancer tissue using CSB-PA269233(ME1 Antibody) at dilution 1/35, on the right is treated with synthetic peptide. (Original magnification: ×200)
-
Gel: 8%SDS-PAGE, Lysate: 40 μg, Lane: A431 cells, Primary antibody: CSB-PA269233(ME1 Antibody) at dilution 1/200, Secondary antibody: Goat anti rabbit IgG at 1/8000 dilution, Exposure time: 15 seconds
-
-
其他:
產品詳情
-
Uniprot No.:
-
基因名:
-
別名:Cytosolic malic enzyme 1 antibody; HUMNDME antibody; Malate dehydrogenase antibody; Malic enzyme 1 antibody; Malic enzyme 1; NADP(+) dependent; cytosolic antibody; Malic enzyme 1; soluble antibody; Malic enzyme; cytoplasmic antibody; MAOX_HUMAN antibody; ME1 antibody; MES antibody; NADP dependent malic enzyme antibody; NADP ME antibody; NADP-dependent malic enzyme antibody; NADP-ME antibody; Pyruvic malic carboxylase antibody
-
宿主:Rabbit
-
反應種屬:Human,Mouse
-
免疫原:Synthetic peptide of Human ME1
-
免疫原種屬:Homo sapiens (Human)
-
標記方式:Non-conjugated
-
抗體亞型:IgG
-
純化方式:Antigen affinity purification
-
濃度:It differs from different batches. Please contact us to confirm it.
-
保存緩沖液:-20°C, pH7.4 PBS, 0.05% NaN3, 40% Glycerol
-
產品提供形式:Liquid
-
應用范圍:ELISA,WB,IHC
-
推薦稀釋比:
Application Recommended Dilution ELISA 1:2000-1:5000 WB 1:200-1:1000 IHC 1:50-1:200 -
Protocols:
-
儲存條件:Upon receipt, store at -20°C or -80°C. Avoid repeated freeze.
-
貨期:Basically, we can dispatch the products out in 1-3 working days after receiving your orders. Delivery time maybe differs from different purchasing way or location, please kindly consult your local distributors for specific delivery time.
-
用途:For Research Use Only. Not for use in diagnostic or therapeutic procedures.
相關產品
靶點詳情
-
基因功能參考文獻:
- Bioinformatics analysis identified that miR612 targeted ME1, which expression was high and inversely associated with miR612 expression in bladder cancer tissues. PMID: 29620192
- Findings indicate that malic enzyme 1 (ME1) is a valid target for molecular therapy in oral squamous cell carcinomas (OSCCs). PMID: 29601126
- these findings uncover a direct cross-talk mechanism between ME1 and PPP, may reveal an alternative model for signaling transduction via protein conformational simulation, and pave the way for better understanding how metabolic pathways are coordinated in cancer. PMID: 28848047
- ME1/ME2 expression phenotype may have a potential to be a valuable marker for sebaceous differentiation in sebaceous lesions. PMID: 26381116
- ME1 expression was found to be mutant-KRAS-associated in NSCLC cancer cell lines. Patients with elevated ME1 had worse outcomes after radiotherapy. Transamination generating cytosolic NADPH via ME1 may contribute to radioresistance. PMID: 26173780
- ME1 overexpression associates with unfavorable prognoses in patients with HCC, suggesting that ME1 is a poor prognostic predictor of hepatocellular carcinoma. PMID: 25753478
- essential role for ME1 in the production of cytosolic NADPH and maintenance of migratory and invasive abilities of nasopharyngeal carcinoma cells PMID: 23114090
- the differential protein stability between dimer and tetramer interface interactions of human c-NADP-ME PMID: 23284632
- p53 represses the expression of the tricarboxylic-acid-cycle-associated malic enzymes ME1 and ME2 in human and mouse cells PMID: 23334421
- cytosolic malic enzyme 1 gene polymorphism is associated with the degree of suppression of parathyroid hormone after long-term calcium supplementation; the effect is probably mediated through an increase in intestinal calcium absorption PMID: 22456781
- ME1 is a functional target gene of the BACH1 transcription factor according to ChIP-seq and knockdown analysis in HEK 293 cells. PMID: 21555518
- that the single mutation of Gln362 to Lys in human m-NAD-ME changes it to an NADP+-dependent enzyme, which is characteristic because it is non-allosteric, non-cooperative, and NADP+-specific PMID: 16757477
- although ME1 overexpression augments anaplerosis and glucose stimulated insulin secretion in INS-1 832/13 cells, it is not likely involved in methyl succinate and glucose stimulated insulin secretion in pancreatic islets PMID: 19293334
- human c-NADP-ME exists mainly as a tetramer, whereas human m-NAD(P)-ME exists as a mixture of dimers and tetramers PMID: 19416979
- A series of R98/D102 mutants examined the possible interactions between Arg98 and Asp102 using double-mutant cycle analysis. Kinetic analysis revealed that the catalytic efficiency of was severely affected by mutating both Arg98 and Asp102 residues. PMID: 19464998
顯示更多
收起更多
-
亞細胞定位:Cytoplasm.
-
蛋白家族:Malic enzymes family
-
組織特異性:Expressed in all tissues tested including liver, placenta and white adipose tissue.
-
數據庫鏈接:
Most popular with customers
-
-
YWHAB Recombinant Monoclonal Antibody
Applications: ELISA, WB, IHC, IF, FC
Species Reactivity: Human, Mouse, Rat
-
Phospho-YAP1 (S127) Recombinant Monoclonal Antibody
Applications: ELISA, WB, IHC
Species Reactivity: Human
-
-
-
-
-